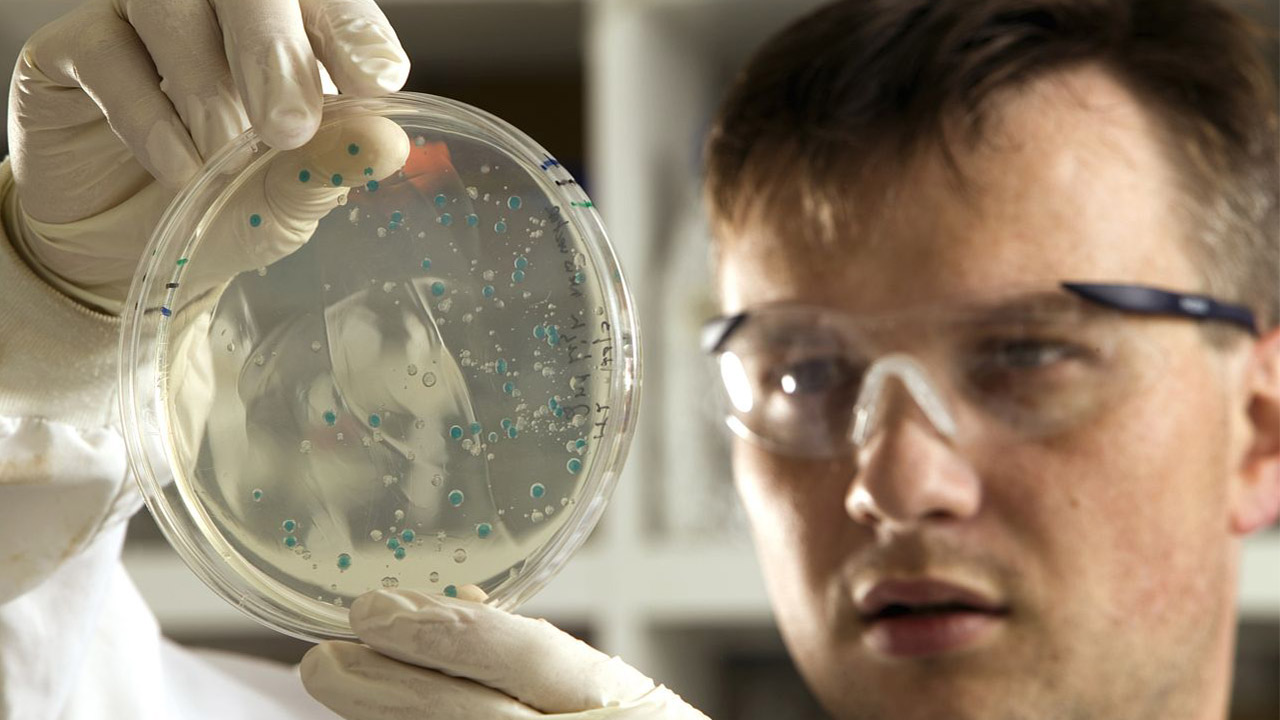

متى تسبب البكتيريا الحلزونية سرطان المعدة، وما أعراضها وعلاجها؟
البكتيريا الحلزونية هي نوع من البكتيريا التي تصيب المعدة، ويمكن أن يسبب تقرحات والتهابات في بطانة المعدة أو الجزء العلوي من الأمعاء الدقيقة (الاثنا عشر) وقد تؤدي العدوى بالنسبة لبعض الأشخاص إلى الإصابة بسرطان المعدة.
تعد العدوى بالبكتيريا الحلزونية مرضًا شائعًا، فحوالي ثلثي سكان العالم لديهم في أجسادهم ولكن بالنسبة لمعظم الناس لا يسبب أي أعراض وفقًا لموقع "Webmd" لكنه السبب الأكثر شيوعًا لـلقرحة الهضمية، وهي تقرحات مفتوحة مؤلمة في الجهاز الهضمي وفي حالات نادرة، يمكن أن يؤدي إلى سرطان المعدة.
كيف تصاب بالبكتيريا الحلزونية؟
عادةً ما تنتشر بكتيريا الملوية البوابية من شخص لآخر ومن المحتمل أيضًا أن تنتقل من خلال:
الطعام أو الماء أو الأواني المتسخة
الفم إلى الفم (التقبيل)
البراز أو القيء الملوث
بمجرد دخول بكتيريا الملوية البوابية إلى الجسم، فإنها تتكاثر في بطانة المعدة، ويؤدي ذلك إلى إضعاف البطانة، مما يزيد من احتمالية تسبب أحماض المعدة في حدوث قرحة.
هل الملوية البوابية معدية؟
نعم، يمكن الإصابة بالبكتيريا الحلزونية إذا لامس الشخص لعاب أو سوائل الجسم الأخرى لشخص مصاب بالفعل.
عوامل الخطر للبكتيريا الحلزونية
يصاب معظم الأشخاص بالبكتيريا الحلزونية أثناء مرحلة الطفولة، ولكن يمكن أن يصاب بها البالغون أيضًا، وغالبًا ما ترتبط العدوى بظروف المعيشية.
تشمل عوامل الخطر ما يلي:
ظروف معيشية مزدحمة
عدم توفر المياه النظيفة وخدمات الصرف الصحي
العيش في أماكن قريبة مع شخص مصاب
العيش في دولة نامية
أعراض البكتيريا الحلزونية
مجرد وجود البكتيريا لا يسبب الأعراض، ولكن من المحتمل أن تلاحظها إذا كنت مصابًا بالتهاب المعدة (التهاب المعدة) أو القرحة الهضمية بسبب بكتيريا الملوية البوابية، والمشكلة الأكثر شيوعًا هي الألم الخفيف أو الحارق في البطن، وقد يأتي هذا الشعور ويذهب، وقد يتفاقم عندما تكون المعدة فارغة، وقد يشعر المريض بتحسن بعد تناول الطعام أو شرب الحليب أو تناول مضاد للحموضة.
تشمل الأعراض الأخرى ما يلي:
الانتفاخ
التجشؤ
انعدام الشهية
الغثيان
القيء
فقدان الوزن دون سبب واضح
متى تحصل على مساعدة الطوارئ
في بعض الأحيان، تنزف القرحة الهضمية في المعدة أو الأمعاء، هذا يمكن أن يكون خطيرا، لذلك يجب اللجوء للطبيب الفور إذا ظهرت هذه الأعراض:
براز دموي، أو أحمر داكن، أو أسود
صعوبة في التنفس
الدوخة أو الإغماء
جلد شاحب
القيء الدموي أو الأسود أو الذي يشبه القهوة المطحونة
ألم شديد وحاد في المعدة
تُعد عدوى الملوية البوابية أيضًا أحد عوامل خطر الإصابة بسرطان المعدة، والذي يكون له أعراض قليلة في البداية، وتكون أعراض كالآتي:
ألم في البطن أو تورم
الانتفاخ
غثيان
فقدان الشهية
الشعور بالشبع بعد تناول كمية قليلة فقط
القيء
فقدان الوزن بدون سبب
براز أسود
علاج البكتيريا الحلزونية
عادةً ما يتم علاج القرحة الناجمة عن الملوية البوابية بمزيج من المضادات الحيوية ومثبط مضخة البروتون (PPI).

العلاج الثلاثي: تظل العلاجات التي تجمع بين مثبطات مضخة البروتون مع اثنين من المضادات الحيوية هي خيارات العلاج الأول للبكتيريا الحلزونية.
لمضادات الحيوية: من المحتمل أن يصف الطبيب مضادين حيويين لمنع البكتيريا من بناء مقاومة لنوع معين.
مثبطات مضخة البروتون (PPIs): تعمل هذه الأدوية على تقليل الحمض الموجود في معدتك عن طريق منع "المضخات" الصغيرة أو الغدد التي تنتجه. وتشمل هذه الأدوية إيسوميبرازول، ولانسوبرازول، وأوميبرازول، وبانتوبرازول، ورابيبرازول.
البزموت سوبساليسيلات: يُنصح غالبًا باستخدام هذا الدواء، الذي يُستخدم غالبًا كعلاج للإسهال دون وصفة طبية، جنبًا إلى جنب مع المضادات الحيوية لتوفير مزيد من الحماية للمعدة.
حاصرات الهيستامين (H-2): تعمل هذه الأدوية على حظر مادة الهستامين الكيميائية، التي تحفز معدتك على إنتاج المزيد من الحمض. وتشمل هذه الأدوية السيميتيدين (تجاميت) والنيزاتيدين (أكسيد AR). تُستخدم حاصرات H-2 فقط عندما لا تتمكن من تناول مثبطات مضخة البروتون.
ونقدم لكم من خلال موقع (فيتو)، تغطية ورصدًا مستمرًّا على مدار الـ 24 ساعة لـ أسعار الذهب، أسعار اللحوم ، أسعار الدولار ، أسعار اليورو ، أسعار العملات ، أخبار الرياضة ، أخبار مصر، أخبار اقتصاد ، أخبار المحافظات ، أخبار السياسة، أخبار الحوادث ، ويقوم فريقنا بمتابعة حصرية لجميع الدوريات العالمية مثل الدوري الإنجليزي ، الدوري الإيطالي ، الدوري المصري، دوري أبطال أوروبا، دوري أبطال أفريقيا، دوري أبطال آسيا ، والأحداث الهامة والسياسة الخارجية والداخلية بالإضافة للنقل الحصري لـ أخبار الفن والعديد من الأنشطة الثقافية والأدبية.
